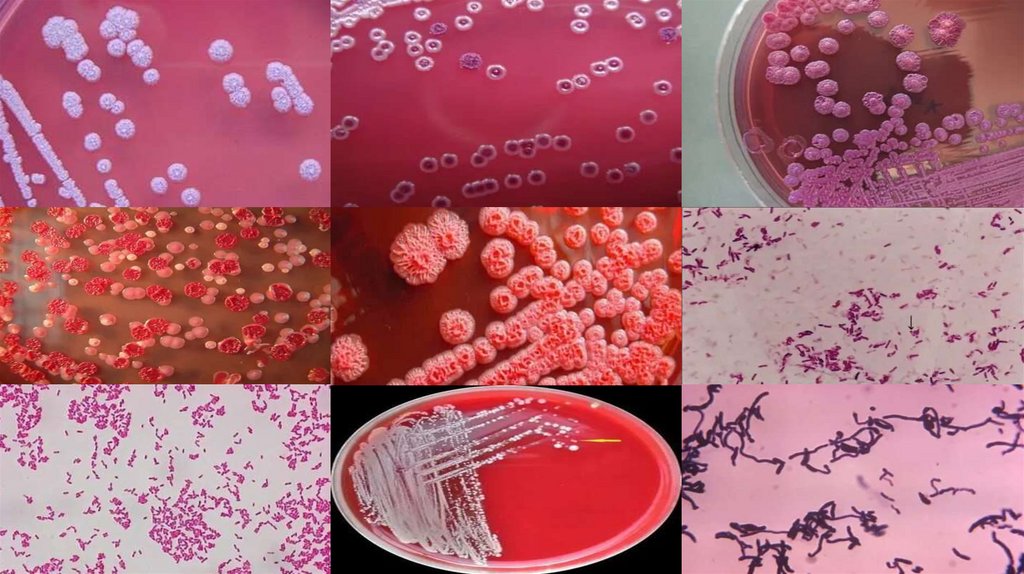

Похожие презентации:
Сап инфекция
1.
Сап инфекция.Сметанин 204
2.
Сап — тяжёлое инфекционное заболеваниелюдей и животных, относящееся к зоонозам.
В основном поражает непарнокопытных —
лошадей, ослов, мулов, зебр, верблюдов.
У человека сап может протекать в острой
или хронической формах. Хронический сап
может принимать кожную, лёгочную или
носовую форму.
3.
Немного истории:Сап —инфекция, которая известна человечеству ещё со
времён Гиппократа.
Первые упоминания о сапе и его описания встречаются в
манускриптах греческих учёных Аристотеля, Апсирта и
Гиппократа
Окончательно бактериальная природа сапа была
установлена в 1882 году немецкими учёными Леффлером и
Шютцем, которые выделили культуру возбудителя болезни
в чистом виде.
4.
Таксономическое положение возбудителя сапа:Burkholderia mallei — вид полиморфных грамотрицательных
неподвижных бактерий рода буркхольдерий (Burkholderia).
Домен: Бактерии.
Тип: Протеобактерии.
Класс: Бета-протеобактерии.
Порядок: Burkholderiales.
Семейство: Burkholderiaceae.
Вид: Burkholderia mallei.
5.
Тинкториальные свойства:Возбудитель сапа (Burkholderia mallei) имеет определённые
тинкториальные свойства. Некоторые из них:
Форма — тонкие, слегка изогнутые палочки с закруглёнными концами
размером 2–3×0,5–1 мкм. В свежих культурах палочки более короткие,
в более старых — более длинные, в виде нитей.
Неподвижность — основной дифференцирующий признак
возбудителя сапа.
Отсутствие спор и капсул.
При выращивании in vitro — склонность к полиморфизму: палочки
образуют более мелкие формы либо цепочки.
Окрашиваются анилиновыми красителями, часто — биполярно.
6.
Культуральные свойства:Условия роста:
-Возбудитель сапа — строгий аэроб.
-Температурный оптимум роста — 37°С, pH 6,8–7,0. Не растёт при
42°С и 5°С.
-Рост усиливается при добавлении к питательным средам 5%
глицерина.
Среда:
-Возбудитель сапа растёт на обычных питательных средах
(мясопептонном агаре и бульоне с добавлением 5% глицерина.)
-На агаровых средах с глицерином образует вязкий слизистый
налёт.(S-форма).
7.
8.
Резистентность сап-инфекцииВозбудитель сапа обладает устойчивостью к
пенициллинам, полимиксинам, ванкомицину,
хиноксидину и диоксидину. В состоянии биоплёнок
культуры B. mallei повышают свою резистентность к
антибактериальным препаратам более чем в 10 раз.
Проблемы лечения определены не только природной
устойчивостью возбудителя к антибактериальным
средствам, но и особенностями патогенеза
заболевания: внутриклеточной локализацией
возбудителя, капсулообразованием, формированием
биоплёнок.
9.
Эпидемиологмия:Источник инфекции для человека — животные,
обычно лошади.
Заражение происходит через выделения больного
животного: носовой секрет, отделяемое кожных язв,
содержимое кишечника, мочу, молоко.
Основной путь инфицирования — контактный (80%)
Заражение человека от животных возможно в
течение всего периода клинических проявлений
болезни животного.
Передача сапа от человека к человеку спорна
Инфекция встречается в некоторых странах Африки,
Азии и Средиземноморья.
10.
ПатогенезВходные ворота — повреждённые кожные покровы
(микротравмы) и слизистые оболочки .
В месте внедрения возникает воспалительная реакция с
вовлечением регионарных лимфатических узлов.
Прорыв возбудителя в кровь приводит к диссеминации его в
различные органы и ткани. Процесс приобретает
септикопиемический характер с образованием метастатических
абсцессов в мышцах и внутренних органах.
В коже, дыхательных путях и лёгких формируется
грануляционно-гнойный процесс.
Характерны гнойные остеомиелиты, артриты, возможно
развитие менингита.
11.
Клиника:-Острая форма сапа у человека имеет инкубационный период от одного до
пяти дней. Некоторые симптомы:
-быстрый подъём температуры тела до 38–39 градусов.
-головная боль.
-резкие боли в мышцах и суставах.
-в месте проникновения возбудителя возникает выраженно окрашенная
папула, которая позднее переходит в типичные для болезни множественные
язвенные поражения.
-Хроническая форма сапа характеризуется медленным развитием и
длительным (от нескольких месяцев до нескольких лет) течением с
обострениями и ремиссиями.
-интоксикация.
-перемежающаяся лихорадка.
12.
Диагностика включает в себя:-клинический осмотр, сбор эпидемиологического анамнеза
-Культуральные методы.
-Полимеразная цепная реакция (ПЦР).
-Бактерии, полученные из отделяемого язв, -содержимого
абсцессов, из мокроты, крови, высаживают на питательные среды,
где наблюдают за их ростом.
-Проба с аллергеном. Подкожно или на скарифицированную кожу
вводят токсин Burkholderia mallei — малеин.Диагноз
подтверждается при развитии у больного через 24–48 часов
аллергической реакции.
-Рентгенография грудной клетки.
13.
ИмунитетПостоянного иммунитета после перенесения
сапа не формируется. Иммунитет при сапе
нестерильный, выражен слабо и только за
счёт клеточных факторов защиты.
Повышение чувствительности организма к
сапным бактериям (аллергия)
устанавливается через 2–3 недели после
естественного заражения.
14.
Лечение:Лечение сапа у человека проводится в инфекционном стационаре. В
качестве этиотропного лечения назначают противомикробные препараты —
сульфаниламиды
другие методы лечения:
Витаминотерапия.
Переливание кровезаменителей.
Оксигенотерапия.
Хирургическое дренирование образовавшихся абсцессов.
Введение глицериновой вытяжки из сапных бацилл (подкожное или
внутрикожное).
Мероприятия интенсивной терапии при септической форме сапа,
направленные на поддержание функции жизненно важных органов.
Лечение лёгких случаев сапа продолжается не менее 30 дней, тяжёлых —
более длительно.
15.
Меры профилактики:-Ветеринарный надзор за лошадьми и другими
однокопытными для своевременного выявления больных
животных.
-облюдение правил личной защиты при уходе за животными с
подозрением на сап
-Дезинфекция мест содержания этих животных.
-Исключение контакта с больными животными.
-В 1940 году сап был окончательно ликвидирован на
территории СССР.

Медицина
Медицина








